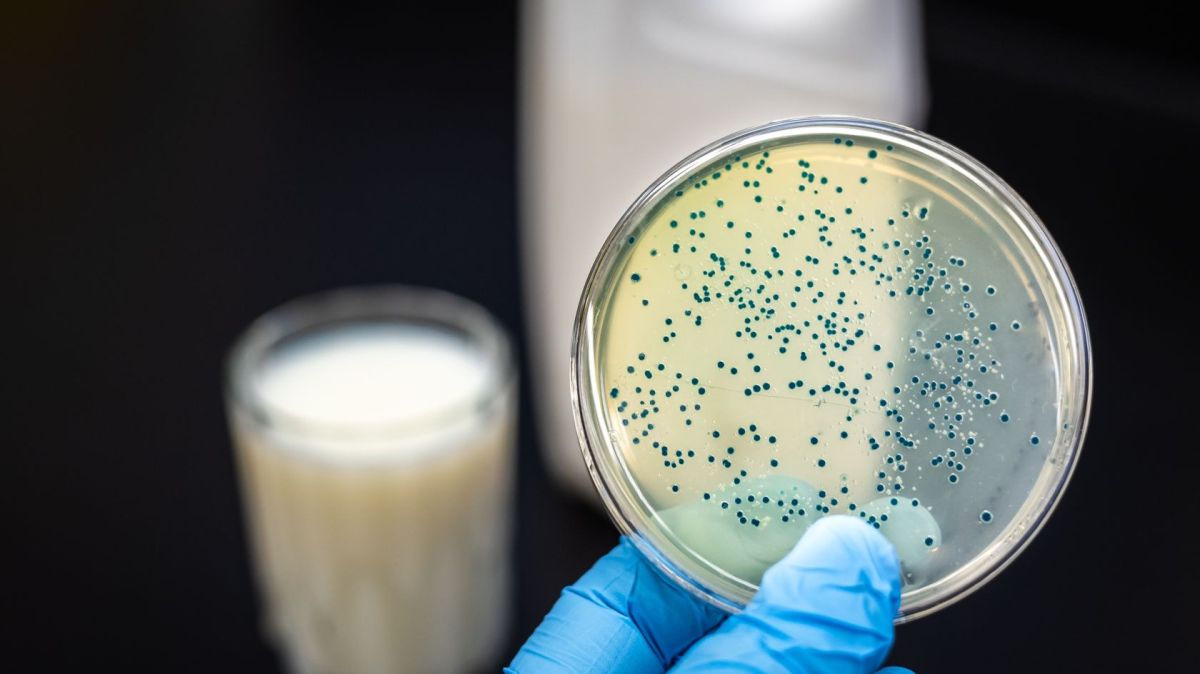

En una breve respuesta enviada a ECO, la compañía franco-holandesa declaró que "tomaba nota de la publicación del pliego de condiciones y del consiguiente inicio oficial del proceso de privatización de TAP Air Portugal".
"Estamos analizando detenidamente las condiciones definidas por el Gobierno y tenemos la intención de presentar nuestra manifestación de interés dentro del plazo indicado", añadió.
Los interesados en la reprivatización del 49,9% de TAP tienen hasta las 16.59 horas del 22 de noviembre para presentar su manifestación de interés en participar en la operación, según un comunicado divulgado por Parpública el martes.
El proceso de venta directa contará con el asesoramiento financiero de Bank of America Europe y Caixa - Banco de Investimento. El asesoramiento jurídico correrá a cargo de Uría Menéndez Abogados.
Además de Air France-KLM, Lufthansa y el grupo IAG, propietario de Iberia y British Airways, también están evaluando la privatización de TAP. Este último se congratuló el martes de los avances en la privatización de TAP y de los términos recientemente publicados, añadiendo que está "analizando cuidadosamente los detalles".
La selección de los candidatos se basará en 11 criterios, definidos en el anuncio, que van desde el precio a la planificación estratégica e industrial, así como el cumplimiento de los compromisos laborales ya asumidos por la aerolínea.